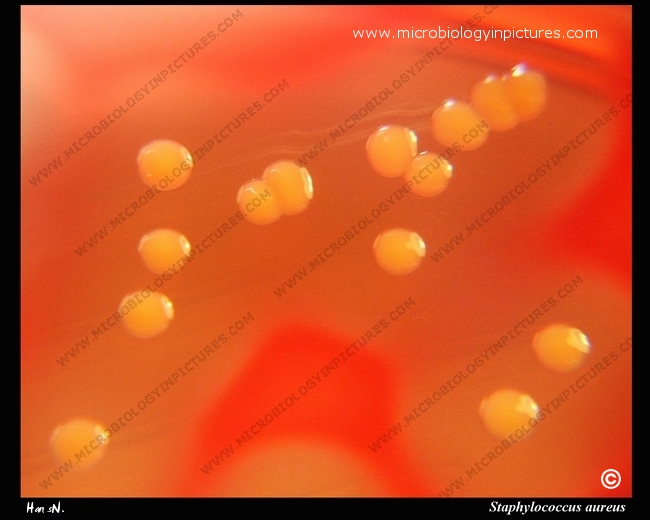
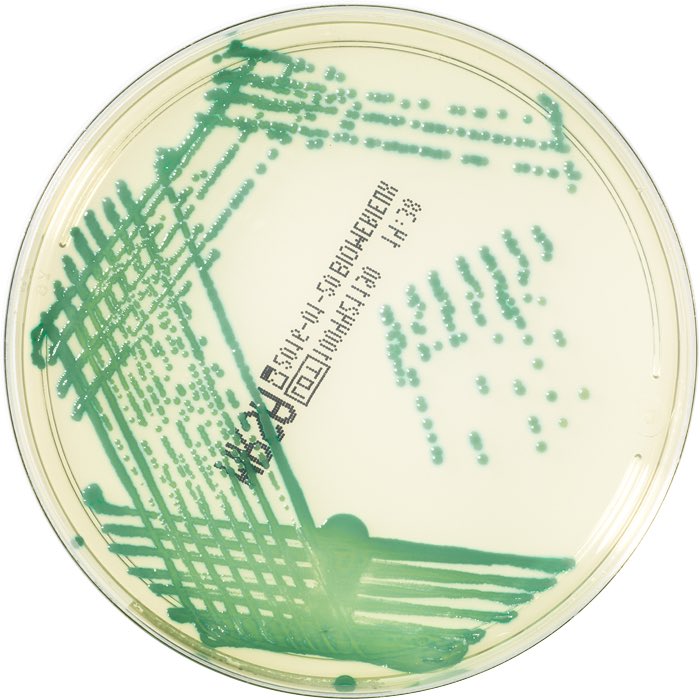

Aureus remix
Северодвинска индустриальная 18 приставы северодвинск
Комбо слово на сегодня
Генеалогический проект
Песня а ты меня любишь конечно
Беркай акгюль биография
Перед засолкой огурцов надо замачивать
Титаны 11 08 2025
Ту продукта это
Номер оператора по теле2
Кулич на пасху в микроволновке
Не плохо сидишь
Трос м66
Боже царя храни царствуй на славу
Aureus remix 114 фотографий